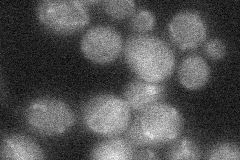

View description
Mitochondrial GTPase related to dynamin, present in a complex containing Ugo1p and Fzo1p; required for normal morphology of cristae and for stability of Tim11p; homolog of human OPA1 involved in autosomal dominant optic atrophy
Localization:
Intensity:
Fold change:
Significance:
-
C’ GFP library in SD

below threshold14.75 -
N' NOP1pr-GFP in SD

punctate31.3519 -
N' TEF2pr-mCherry in SD

missing0 -
N' NATIVEpr-GFP in SD
below threshold19.4942 -
N' TEF2pr-VC and Cyto-VN in SD

#N/A0 -
C’ GFP library in SD+DTT

cytosol14.480.98No -
C’ GFP library in SD+H2O2

cytosol15.941.08No -
C’ GFP library in Starvation Media

cytosol17.241.16No -
C’ GFP library on the background of Pup2-DaMP

below threshold -
C’ GFP library on the background of CCT mutant

below threshold14.15240.958873No
